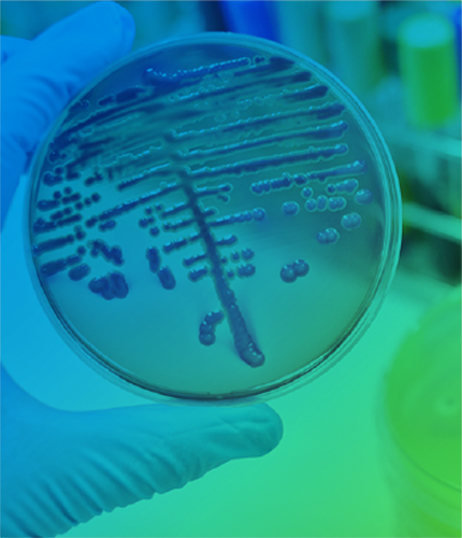

地球上存在的200万种化合物中,1/5具有气味,约有1万种为重要的恶臭物质。恶臭兼有“恶臭污染”和“有害气体污染”的双重特征,属于典型的扰民污染,也是当前投诉的焦点污染物,也被很多学者认为是世界公认的七大公害之一。恶臭物质种类众多,据统计有4000多种,特别是化工、制药、食品加工、垃圾处理等行业排放的恶臭物质少则十几种,多达上百种。

《恶臭污染物排放标准》(GB 14554)

APPLICABLE TECHNOLOGY

Copyright © 2009-2021,www.hanshantech.com,All rights reserved浙公网安备 33010902001043号浙ICP备12039693号-1
